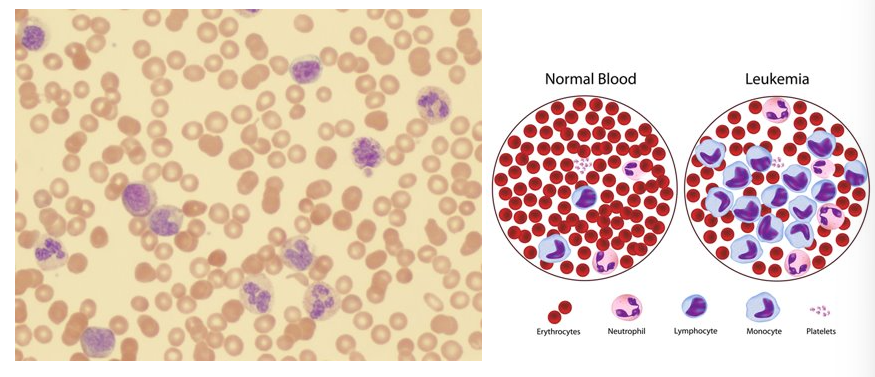
<p>type of blood cancer; high levels of abnormal leukocytes (WBCs)</p>

Lab 1 (Current Draft)
1/37
There's no tags or description
Looks like no tags are added yet.
Name | Mastery | Learn | Test | Matching | Spaced | Call with Kai |
|---|
No analytics yet
Send a link to your students to track their progress
38 Terms
functions of blood
transportation of gases, nutrients, vitamins, hormones, etc
regulation of tissue pH, temperature, etc. throughout the body
immune protection
what type of tissue is blood?
connective tissue
homogenous components of blood
blood plasma (this is the liquid containing water, proteins, and solutes)
formed elements (erythrocytes and buffy coat)

buffy coat
the thin white layer in centrifuged blood samples containing leukocytes (WBCs) and platelets
Leukocytes most common to least common
Neutrophil, Lymphocyte, Monocyte, Eosinophil, and Basophil (Never let monkeys eat bananas)
Granular leukocytes
contains conspicuous cytoplasmic granules that appear upon staining;
types include:
neutrophil
eosinophil
basophil

Agranular leukocytes
has cytoplasmic granules but they do not appear with staining (they’re inconspicuous!)
types include:
monocyte
lymphocyte

neutrophils
55-65% of all WBCs
polymorphonuclear
Function:
destroy bacteria by phagocytosis
chemically attracted to sites of inflammation

lymphocyte
25-35% of all WBCs
large nucleus that occupies most of the cell’s volume; variable in size
Function:
B-cells: give rise to antibody-producing cells
T-cells: directly attack virus-infected cells, transplanted cells, cancer cells, and some bacteria
Increases in number following infection and immune response

monocyte
3-7% of all WBCs
kidney-shaped nucleus; largest of the WBCs
Function:
once they leave the capillaries these cells transform into wandering macrophages
macrophages phagocytize pathogens and dead tissue

Eosinophil
1-3% of WBCs
Nucleus 2-3 lobes connected by thin strand; granules appear red-orange with acidic dye
Function:
targets certain parasitic worms
gather around worm, and releases digestive chemicals from granules
also has complex role in allergic responses and asthma

Basophil
<1% of WBC (rare)
large dark purple, irregularly sized granules; nucleus is irregularly shaped bi-lobed, however obscured from view by granules when stained
Function:
involved in inflammatory and allergic reactions - release histamine
counts increase w/ allergic rxns, leukemia, diabetes, and autoimmune disorders

Leukemia
type of blood cancer; high levels of abnormal leukocytes (WBCs)
platelets
anucleate cell fragments
small: 2-4 microns
aids in stopping blood loss by:
forming platelet plug
releasing chemicals that promote blood clotting
releasing chemicals that promote vascular spasm
contraction of smooth muscle in artery/arteriole walls
formed by splintering of megakaryocytes in red bone marrow.


what are labels (top to bottom)
blood plasma, buffy coat (platelets and WBCs), RBCs
erythrocytes (RBCs)
most common formed element
anucleate and missing most other organelles
7-8 microns, disc shaped
contains the protein hemoglobin
carries O2 and CO2
iron is essential

hemoglobin
transports oxygen, found in erythrocytes (RBCs)
metalloprotein — each heme site has an iron (Fe) ion
undergoes a conformational change as O2 binds to the heme site of each subunit (4 total)

hematopoiesis
blood formation

hemocytoblasts form:
myeloid stem cell and lymphoid stem cells
lymphoid stem cells make:
lymphocytes (T-cells, B-cells →plasma cell, and natural killer cells)
myeloid stem cells make:
“everything else” (all of the rest of the formed elements that lymphoid cells don’t produce)
Hematocrit (aka Packed Cell Volume-PCV)
a rough measure of oxygen carrying ability of the blood
% of RBCs/total blood volume
normal females = 42%; normal males = 47%
to measure fill capillary tube w/ heparinized blood and centrifuge → formed elements separate from plasma → determine packed cell volume (PCV)
polycythemia
abnormally high hematocrit; higher than normal volume of RBCs (>55%)
hemoglobin concentration [Hb]
more direct (“better” than PCV) assessment of oxygen carrying ability compared to hematocrit
measured using spectroscopy
less light is able to transmit through a hemoglobin rich sample
anemia
reduced oxygen carrying ability of the blood
Causes include:
aplastic anemia: caused by failure of red bone marrow to produce RBCs
iron deficiency anemia: decrease in hemoglobin production due to inadequate iron
sickle cell anemia: inherited condition in which hemoglobin is misshapen, resulting in reduced oxygen carrying capacity
Draw out ABO Blood System table

blood plasma contains antibodies that react with ___ ___ found on the RBCs of the individual
blood plasma contains antibodies that react with antigens NOT found on the RBCs of the individual
Universal donor + Universal recipient
O- ; AB+
Who has anti-Rh antibodies?
Rh- individuals but only after exposure to Rh+ blood
What are the component of blood

hormones
a regulatory substance that stimulates cell and tissues
cytokines
a secreted substance that causes an effect on other cells, used here to refer to signaling compounds for WBC production
erythropoietin (EPO)
a hormone released by kidney fibroblasts when oxygen levels are low in the kidney, causing erythroid progenitor cells to grow, not die (EPO inhibits apoptosis), and induce differentiation to make more RBCs
erythropoiesis
the process that describes the formation of red blood cells from stem cells
reticulocytes
the immature form of RBCs
blood type
determined by the presence or absence of specific antigens (glycoproteins)
agglutination
the process that occurs when a specific antigen mixes with its corresponding antibody
antibodies
plasma proteins that attack specific antigens and destroy the cells bearing those antigens or make cellular destruction easier